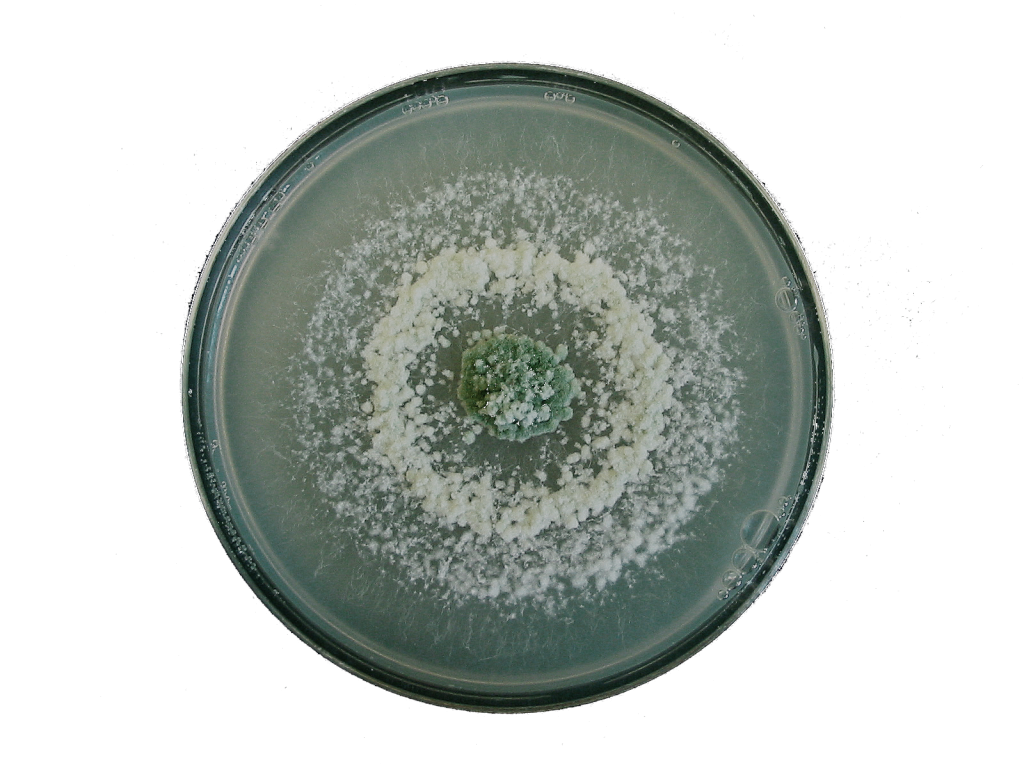

Conceptos generales sobre Trichoderma spp.
¿Todos los 'Trichodermas' son lo mismo?
1. Introducción
En esta entrada de blog, encontrarás la información necesaria para conocer más de cerca al género Trichoderma, así como algunos aspectos relacionados.
El fitosanitario (o Plant Protection Product, PPP) T34 Biocontrol®, es un producto natural basado en el microorganismo Trichoderma asperellum, cepa T34.
Son muchas las cualidades que presenta para la producción agrícola, el medio ambiente y la salud de los consumidores. Todas ellas están respaldadas por los numerosos estudios llevados a cabo para su registro como PPP biológico (ensayos de eficacia, ensayos de toxicidad, ecotoxicidad), publicaciones científicas en revistas internacionales y el testimonio de los agricultores que confían en nuestro producto.
PPP o Plant Protection Products
El Reglamento Europeo sobre productos fitosanitarios 1107/2009 utiliza la siguiente definición: ‘productos, en la forma en que se suministran al usuario, que consisten en o contienen sustancias activas, protectores o sinergistas, y están destinados a uno de los siguientes usos:
- La protección de plantas o productos vegetales contra todos los organismos nocivos.
- Sustancias que influyen en los procesos de vida de las plantas.
- Sustancias que influyen en su crecimiento, que no sea como un nutriente.
- El almacenamiento de productos vegetales.
- La destrucción de plantas o partes de plantas no deseadas.
- La limitación o prevención del crecimiento no deseado de las plantas.
2. ¿Qué es exactamente Trichoderma?
Como hemos comentado en blogs anteriores, la taxonomía es la ciencia que se encarga de ordenar y clasificar a todos los seres vivos, tanto animales como vegetales. Se aplica en biología, para la ordenación jerarquizada y sistemática, con sus nombres de animales y de vegetales.
A continuación, os presentamos la clasificación taxonómica de Trichoderma spp:

3. Distribución
Predominan en los ecosistemas terrestres, en concreto en suelos agrícolas, aunque también se pueden encontrar en ambientes acuáticos (Zhang et al 2005).
Dentro de este género se encuentran especies que pueden ser: de vida libre en el suelo, oportunistas, simbiontes de planta o micoparásitas.
Estos hongos filamentosos tienen bajos requerimientos nutricionales, su crecimiento se ve favorecido por la materia orgánica, la humedad y la temperatura, todo y que crecen en un amplio rango de temperaturas (0 a 40 ̊C), el crecimiento óptimo para muchas especies se encuentra entre el 25 a 30º C (Papavizas 1985: Trichoderma and Gliocladium: Biology, Ecology, and Potential for Biocontrol. Daryaei 2016).
4. Morfología





5. ¿Qué es una cepa?
Cuando hablamos de T34 Biocontrol®, hacemos bastante énfasis enrecalcar que se trata de la exclusiva cepa patentada T34 de Trichoderma asperellum.
Esta cepa, la número 34, se seleccionó de entre más de 200 cepas de Trichoderma spp. Por lo que fue minuciosamente escogida por las propiedades que ofrecía, siendo ésta la cepa con una supresión más alta que la competencia.
Si bien, este dato es tan importante como para incluirlo en el nombre del fitosanitario, debemos entender a qué nos referimos cuando hablamos de cepa.
Según la RAE (Real Academia de la lengua Española), una cepa es un grupo de organismos emparentados, como las bacterias, los hongos o los virus, cuya ascendencia común es conocida.
Una cepa, en microbiología, hace referencia al conjunto de microorganismos que pertenecen a una misma especie y que provienen de una única célula o muestra en particular. Las cepas, además, pueden ser multiplicadas y expandidas clonalmente dependiendo del interés en su conservación. (Fuente).
Según la RAE

Según la RAE (Real Academia de la lengua Española), una cepa es un grupo de organismos emparentados, como las bacterias, los hongos o los virus, cuya ascendencia común es conocida.
En Microbiología
Hace referencia al conjunto de microorganismos que pertenecen a una misma especie y que provienen de una única célula o muestra en particular.
Las cepas, además, pueden ser multiplicadas y expandidas clonalmente dependiendo del interés en su conservación. (Fuente).
6. ¿Todas las cepas son iguales?
No, cada cepa es única y no todas comparten las mismas propiedades. Por este motivo el registro como PPP se hace a nivel de cepa que equivale a una substancia activa, por tanto, sus características biológicas y su eficacia en el control de enfermedades es específica y única.

Según el artículo:
Evolution and comparative genomics of the most common Trichoderma species
“La divergencia entre las dos cepas de T. harzianum (es decir, una de Europa, Reino Unido, y uno de América del Sur, Brasil) se calculó haber ocurrido hace 460. 000 años. La especiación de T. afroharzianum y T. guihouense pueden fecharse alrededor de 5-6 Millones de años, que es comparable a la de T. reesei y T. parareesei, lo que justifica su reconocimiento como especies separadas.”
6. ¿Qué ventajas tiene la cepa T34?
Entre las ventajas que presenta la cepa T34 del género Trichoderma spp.:
- Presenta múltiples mecanismos de acción:
a) Es eficaz frente a un amplio espectro de patógenos.
b) No genera resistencias, por lo que su uso continuado va a tener el mismo efecto (o incluso se podría ver potenciado).
c) No solo protege a los cultivos, además, se ha demostrado que es un excelente promotor de crecimiento.
Tras la aplicación del producto, en pocas semanas se ha visto que hay un sistema radicular mucho más desarrollado. En el estudio de Physyiologcical effects of the induction of resistance by compost or Trichoderma asperellum strain T34 against Botrytis cinérea in tomato, se observó que la zona radicular era dos veces mayor en las plantas donde se había aplicado T34, además el área foliar era un 60% mayor y hubo un incremento de la altura del 25% y del peso del 80%.
d) También ayuda a absorber mejor los nutrientes, en el estudio de Biological Control realizado en 2014 ( es el mismo estudio que menciono en el párrafo anterior) se demostró que el uso del fitosanitario estaba relacionado con un aumento en la absorción de nutrientes, y por consecuencia, un aumento de la producción de los cultivos.
e) Este fitosanitario es un producto respetuoso con el medio ambiente. La mayoría de los químicos suelen “limpiar el suelo” eliminando la microbiota y fauna presente, mientras que T34 Biocontrol ® no altera la composición del medio.
f) T34 No tiene Limite Máximo de Residuo: es considerado un producto inocuo para la salud humana, ya que no afecta la salud del aplicador ni del consumidor. Es un agente de control perfecto para aplicar en fruta y verdura para su posterior exportación a la Unión Europea.
T34 Biocontrol®, según el Diario Oficial de la Unión Europea 12.6.2015 es un producto al que no se exige Límite Máximo de Residuos (LMR https://www.efsa.europa.eu/es/glossary/maximum-residue-level-pesticides ) por la Regulación (EC) 396/2005, así “no se considera patogénico para los humanos y no se espera que produzca toxinas que sean importantes para la salud humana”.
7. T34 Biocontrol®: De uso preventivo y curativo.
d) También ayuda a absorber mejor los nutrientes, en el estudio de Biological Control realizado en 2014 ( es el mismo estudio que menciono en el párrafo anterior) se demostró que el uso del fitosanitario estaba relacionado con un aumento en la absorción de nutrientes, y por consecuencia, un aumento de la producción de los cultivos.
e) Este fitosanitario es un producto respetuoso con el medio ambiente. La mayoría de los químicos suelen “limpiar el suelo” eliminando la microbiota y fauna presente, mientras que T34 Biocontrol ® no altera la composición del medio.
f) T34 No tiene Limite Máximo de Residuo: es considerado un producto inocuo para la salud humana, ya que no afecta la salud del aplicador ni del consumidor. Es un agente de control perfecto para aplicar en fruta y verdura para la exportacion a la UE.
Cuando hablamos de que el biofungicida tiene un uso preventivo y curativo, nos referimos a que:
Preventivo.
Porque es un microorganismo que se establece en la rizosfera de la planta y crea un ambiente muy favorable en el que comparte y facilita a la planta la captación de minerales del suelo, la colonización previa por parte de T34 impide la entrada del patógeno.
Curativo.
Porque en el caso de haber la presencia de fitopatógenos, la cepa T34 puede proteger a la planta mediante diferentes estrategias, como estrangulamiento de las hifas y degradación de las estructuras de resistencia de algunos patógenos (esclerocios, clamidosporas, conidios).
8. ¿Qué significa el término Biocontrol?
Hay dos géneros de microorganismos que se utilizan mucho como PPP biológicos, Bacillus spp. y Trichoderma spp. El término Biocontrol, se refiere a la capacidad de algunas de las cepas de estos organismos para controlar/reducir enfermedades / plagas de las plantas.
El fitosanitario T34Biocontrol®, tiene los siguientes modos de acción:
Efecto directo sobre patógenos de las plantas:
- competencia por espacio y/o nutrientes
- Parasitismo
- Antagonismo (sustancias biostáticas / biocidas)
Efecto sobre la planta:
estimulación de las respuestas de defensa o sistema inmune.
8. Aplicaciones de Trichoderma spp. en otros sectores industriales
Los miembros del género Trichoderma tienen el potencial de sintetizar y liberar enzimas como polisacarasas, celulasas, xilanasas y quitinasas, las cuales se han aprovechado en procesos industriales (Kubicek y Harman 1998 Trichoderma And Gliocladium: Basic Biology, Taxonomy and Genetics – Google Libros, Verma et al. 2007).
La explotación comercial de estas enzimas es diversa, ya que se emplean para producir detergente de ropa, aceite de oliva, vino, cerveza, jugos, alimentos para animales y en la producción de algunos combustibles (Reese y Mandels 1989, Galante et al. 1993, Walsh et al. 1993, Verma et al. 2007).
Por ejemplo, las celulasas de T. reesei se utilizan en el blanqueo de pulpa de papel, y son una alternativa amigable al convencional blanqueo con cloro, evitando el problema ambiental del cloro generado por dicho proceso (Buchert et al. 1994)


Si quieres saber más, apúntate al próximo seminario online gratuito!
No te lo pierdas!